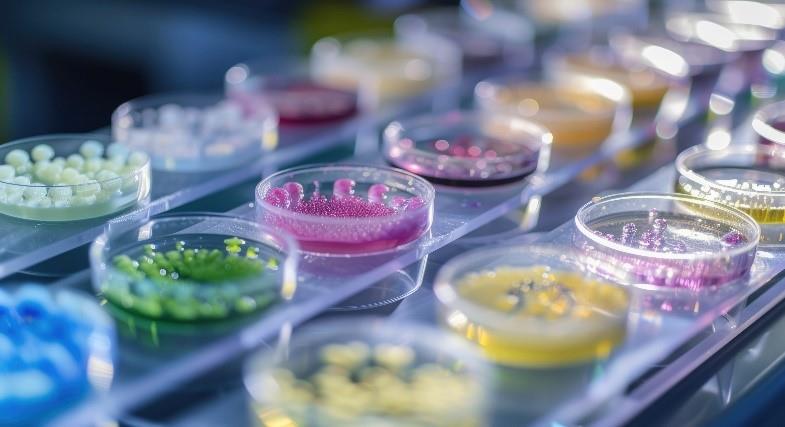
تحقیق و پژوهش در مورد بیماری‌ها در آزمایشگاه پاتوبیولوژی

5 نکته کلیدی درباره آزمایشگاه پاتوبیولوژی و نقش آن در تشخیص
آزمایشگاه پاتوبیولوژی یکی از مهم ترین بخشهای علوم پزشکی است که به مطالعه و تشخیص بیماریها از طریق بررسی بافتها و سلولها اختصاص دارد. این آزمایشگاه با استفاده از تکنیکهای پیشرفته و تجهیزات خاص، نمونههای بیولوژیکی را تجزیه و تحلیل میکند تا به شناسایی بیماریها، ارزیابی شدت آنها و تعیین روند درمان کمک نماید. در این مقاله به بررسی موضوعاتی از قبیل روشهای اصلی در آزمایشگاه پاتوبیولوژی و نمونهبرداری و کلید تشخیص صحیح، خواهیم پرداخت.
آزمایشگاه پاتوبیولوژی: قلب تشخیص بیماریها
پاتوبیولوژی به مطالعه تغییرات بافتی و سلولی ناشی از بیماریها میپردازد. این علم به پزشکان کمک میکند تا نهتنها نوع بیماری را شناسایی کنند، بلکه شدت و مراحل پیشرفت آن را نیز ارزیابی نمایند. باتوجه به پیشرفتهای تکنولوژیکی، آزمایشگاههای پاتوبیولوژی اکنون میتوانند از تکنیکهای پیشرفتهای مانند ایمونو هیستوشیمی، میکروسکوپ الکترونی و روشهای مولکولی، بهرهبرداری کنند.
به گفته وب سایت pvd درباره میکروسکوپ الکترونی ؛ دستهای از میکروسکوپها که از پرتویی از الکترونهای شتابدار به عنوان منبع تابش استفاده میکنند، میکروسکوپهای الکترونی نامیده میشوند.

فرآیند کار در این آزمایشگاهها شامل جمعآوری نمونهها، آمادهسازی آنها برای بررسی، تحلیل و گزارش نتایج است. نمونهها میتوانند شامل بافتهای برداشته شده از جراحی، نمونههای خون و مایعات بدن باشند. پس از بررسی دقیق، نتایج به پزشکان ارسال میشود تا بر اساس آنها تصمیمات درمانی مناسب اتخاذ گردد.
نقش پاتوبیولوژی در پزشکی مدرن
پاتوبیولوژی بهعنوان یکی از ارکان کلیدی در پزشکی مدرن، تأثیر عمیق و گستردهای بر فرآیند تشخیص، درمان و پیشگیری از بیماریها دارد. این علم با تحلیل تغییرات بافتی و سلولی ناشی از بیماریها، اطلاعات حیاتی را برای پزشکان فراهم میآورد. در ادامه به برخی از نقشهای اساسی پاتوبیولوژی در پزشکی مدرن اشاره میشود:
بیشتر بخوانید: بهترین رشته های علوم پایه پزشکی
- تشخیص دقیق بیماریها
پاتوبیولوژی به پزشکان کمک میکند تا با بررسی نمونههای بافتی و سلولی، نوع و مرحله بیماری را شناسایی کنند. این تشخیص دقیق، بهویژه در زمینه بیماریهایی مانند سرطان، اهمیت ویژهای دارد. تشخیص بهموقع میتواند تأثیر مستقیمی بر نتایج درمانی و بقا بیمار داشته باشد.
- راهنمایی در درمانهای شخصیسازی شده
باتوجه به پیشرفتهای علمی در زمینه بیومارکرها و ژنتیک، پاتوبیولوژی به پزشکان این امکان را میدهد که درمانهای هدفمندی را بر اساس ویژگیهای خاص هر بیمار طراحی کنند. این رویکرد شخصی سازی شده میتواند به بهبود نتایج درمانی و کاهش عوارض جانبی کمک نماید.
- پیشگیری از بیماریها
پاتوبیولوژی به شناسایی عوامل خطر و پیش بینی روند پیشرفت بیماریها کمک میکند. با ارزیابی دقیق نمونهها، میتوان به شناسایی بیماریهای زمینهای و اتخاذ تدابیر پیشگیرانه پرداخت.
بیشتر بخوانید: 0 تا 100 رشته ویروس شناسی پزشکی و بازار کار آن
- تحقیق و توسعه
پاتوبیولوژی بهعنوان یک زمینه تحقیقاتی مهم، به توسعه درمانهای جدید و نوآوریهای پزشکی کمک میکند. با مطالعه مکانیزمهای بیماری زایی و اثرات درمانها، این علم به پیشرفتهای علمی و بهبود روشهای درمانی منجر میشود.
- پشتیبانی از تصمیمگیری بالینی
نتایج آزمایشهای پاتولوژیک به پزشکان این امکان را میدهد که تصمیمات بهتری در مورد درمان و مراقبت از بیماران اتخاذ کنند. این اطلاعات میتواند به انتخاب بهترین روشهای درمانی و مدیریت بیمار کمک نماید.
پاتوبیولوژی در پزشکی مدرن بهعنوان یک علم کلیدی، نقشی بیبدیل در تشخیص، درمان و پیشگیری از بیماریها، ایفا میکند.
روشهای اصلی در آزمایشگاه پاتوبیولوژی
آزمایشگاه پاتوبیولوژی بهعنوان قلب تشخیص بیماریها، از روشهای متنوع و پیشرفتهای برای تجزیهوتحلیل نمونههای بیولوژیکی استفاده میکند. این روشها به شناسایی دقیق و مؤثر بیماریها کمک مینماید. در ادامه به برخی از روشهای اصلی در آزمایشگاه پاتوبیولوژی اشاره میشود:
بیشتر بخوانید: هر آنچه که باید در خصوص ژن و ژنتیک بدانید
- بیوپسی (Biopsy)
بیوپسی شامل برداشتن بافت از ناحیه مشکوک به بیماری برای بررسی دقیق است. این روش میتواند بهصورت:
- بیوپسی سوزنی: استفاده از سوزن برای برداشت نمونههای کوچک بافت.
- بیوپسی جراحی: برداشتن بخشی یا تمام یک توده برای بررسی.

- رنگآمیزی بافت (Tissue Staining)
رنگآمیزی بافت بهمنظور مشاهده و تشخیص تغییرات سلولی و بافتی انجام میشود. رایجترین روشهای رنگآمیزی عبارتاند از:
- رنگآمیزی هماتوکسیلین - ائوزین: یکی از متداولترین روشها که به شناسایی ساختارهای بافتی کمک میکند.
- رنگآمیزی ویژه: مانند رنگآمیزیای که برای شناسایی باکتریها یا قارچها استفاده میشود.
- ایمونو هیستوشیمی (Immunohistochemistry)
این روش از آنتی بادیهای خاص برای شناسایی پروتئینهای ویژهای در بافت استفاده میکند. این تکنیک به شناسایی انواع سلولها و تغییرات مرتبط با بیماریها کمک مینماید و بهویژه در تشخیص سرطانها کاربرد دارد.
بیشتر بخوانید: کتاب های ایمونولوژی
- میکروسکوپی الکترونی (Electron Microscopy)
میکروسکوپی الکترونی به بررسی ساختارهای سلولی در مقیاس نانو کمک میکند و برای شناسایی تغییرات دقیق در بافتها و سلولها استفاده میشود. این روش بهویژه برای بررسی بیماریهای خاص و نادر مؤثر است.
- روشهای مولکولی (Molecular Techniques)
این روشها شامل تکنیکهایی مانند PCR (واکنش زنجیرهای پلیمراز) و توالییابی DNA هستند که برای شناسایی تغییرات ژنتیکی و بیومارکرهای بیماریها استفاده میشوند. این تکنیکها به تشخیص زودهنگام و درمانهای هدفمند، کمک میکنند.
- سیتولوژی (Cytology)
سیتولوژی به مطالعه سلولها بهصورت جداگانه میپردازد و میتواند به تشخیص بیماریها از جمله سرطان کمک کند. نمونههای سیتولوژی معمولاً از مایعات بدن یا بافتهای سطحی، جمعآوری میشوند.
به گفته وب سایت fardalab سیتولوژی بخشی از پاتولوژی است که به بررسی و تشخیص بیماری در سطح سلول می پردازد.

روشهای اصلی در آزمایشگاه پاتوبیولوژی به طور گستردهای برای تشخیص و ارزیابی بیماریها به کار میروند. این روشها به پزشکان کمک میکنند تا تصمیمات بهتری در مورد درمان و مراقبت از بیماران اتخاذ نمایند. با پیشرفتهای تکنولوژیکی در این زمینه، انتظار میرود که دقت و سرعت تشخیص بیماریها به طور چشمگیری افزایش یابد.
بیشتر بخوانید: کتاب های انگل شناسی
چه نوع آزمایشهایی در آزمایشگاه پاتوبیولوژی انجام میشود؟
آزمایشهای پاتوبیولوژی به طور خاص برای تشخیص انواع مختلف بیماریها مورداستفاده قرار میگیرند. در ادامه به برخی از بیماریهای خاصی که با استفاده از این آزمایشها تشخیص داده میشوند، اشاره میشود:
- سرطان
آزمایشهای بیوپسی و سیتولوژی به تشخیص انواع مختلف سرطانها (مانند سرطان سینه، روده بزرگ، پروستات و...) کمک میکنند.
- عفونتها
آزمایشهای میکروبیولوژی برای شناسایی عفونتهای باکتریایی، ویروسی و قارچی، مانند عفونتهای تنفسی، عفونتهای ادراری و...
- بیماریهای خودایمنی
آزمایشهای خاصی برای شناسایی بیماریهایی مانند لوپوس و آرتریت روماتوئید که بهوسیله بررسی بافتها و سلولها انجام میشود.

- بیماریهای التهابی
پاتولوژی میتواند در تشخیص بیماریهای التهابی مزمن مانند بیماری کرون و کولیت اولسراتیو مفید باشد.
- بیماریهای غددی
آزمایشهای پاتوبیولوژی در تشخیص اختلالات غددی مانند بیماری تیروئید و اختلالات هورمونی کاربرد دارند.
بیشتر بخوانید: کتاب های انگل شناسی
- بیماریهای قلبی
نمونهبرداری از بافت قلب بهمنظور تشخیص مشکلات ساختاری یا بیماریهای قلبی خاص.
- بیماریهای کبد و کلیه
بررسی بافتهای کبد و کلیه برای تشخیص مشکلاتی مانند سیروز و نارسایی کلیوی.
- بیماریهای ژنتیکی
برخی آزمایشهای مولکولی میتوانند به شناسایی اختلالات ژنتیکی کمک کنند.
این آزمایشها به پزشکان کمک میکنند تا تشخیص دقیقتری از وضعیت بیمار داشته باشند و طرح درمان مناسبی را ارائه دهند.
نمونهبرداری؛ کلید تشخیص صحیح
نمونهبرداری یکی از مراحل حیاتی و اساسی در فرآیند تشخیص بیماریها در آزمایشگاه پاتوبیولوژی است. کیفیت و دقت نمونهها، تأثیر مستقیمی بر نتایج تشخیصی دارد. نمونه برداری صحیح میتواند به شناسایی دقیق نوع بیماری و مراحل آن کمک کند و به پزشکان اجازه میدهد تا روشهای درمانی مناسبی را انتخاب نمایند.
همچنین، نمونههای نامناسب میتوانند منجر به تشخیصهای نادرست و درمانهای غیرمؤثر شوند؛ بنابراین، نمونهبرداری صحیح به کاهش این ریسک کمک میکند. با نمونهبرداری منظم و صحیح، میتوان تغییرات در وضعیت بیمار را پیگیری کرده و در صورت لازم، تغییرات درمانی را اعمال کرد.
بیشتر بخوانید: کتاب های زیست شناسی

آینده تشخیص بیماریها با پاتوبیولوژی دیجیتال
پاتوبیولوژی دیجیتال به استفاده از فناوریهای دیجیتال برای جمعآوری، ذخیرهسازی، تجزیه و تحلیل و بهاشتراک گذاری تصاویر بافتی و نتایج آزمایشهای پاتولوژی اشاره دارد. این فناوری بهسرعت در حال تحول و گسترش است و میتواند بهعنوان یک ابزار قدرتمند در تشخیص بیماریها و بهبود روندهای درمانی، عمل کند.
از جمله مزایای پاتوبیولوژی دیجیتال میتوان بهدقت و سرعت بیشتر در تشخیص، دسترسی آسان و بهاشتراکگذاری تصاویر و نتایج، تحلیل هوش مصنوعی برای شناسایی تغییرات سلولی و بافتی، آرشیو و نگهداری بهتر اطلاعات و همچنین استفاده بهعنوان ابزارهای آموزشی اشاره کرد. بااینحال، چالشهایی همچون هزینههای اولیه، حفظ حریم خصوصی و امنیت دادهها و نیاز به آموزش کارکنان نیز وجود دارد.
چالشهای پیش روی آزمایشگاههای پاتوبیولوژی
آزمایشگاههای پاتوبیولوژی بهعنوان بخشهای کلیدی در تشخیص و مدیریت بیماریها با چالشهای متعددی مواجه هستند. از جمله چالشها میتوان به هزینههای بالای تجهیزات و فناوری اشاره کرد که تأمین و نگهداری آنها نیاز به سرمایهگذاری قابلتوجهی دارد. مدیریت دادهها و امنیت اطلاعات نیز یکی از چالشهای مهم است که با دیجیتالیشدن اطلاعات پزشکی، حفاظت از حریم خصوصی بیماران را ضروری میسازد.
رقابت با روشهای تشخیصی جدید، مانند تستهای سریع و بیومارکرها، از دیگر چالشها به شمار میروند. علاوه بر این، رعایت قوانین و استانداردهای بالینی و علوم آزمایشگاهی نیاز به منابع و زمان اضافی دارد که میتواند بر عملکرد آزمایشگاهها تأثیر بگذارد.
بیشتر بخوانید: کتاب های خون و انکولوژی
سخن پایانی
آزمایشگاههای پاتوبیولوژی بهعنوان پایهگذار تشخیص بیماریها و ارزیابی وضعیت سلامت بیماران، نقش حیاتی در نظامهای بهداشتی ایفا میکنند. باتوجهبه چالشهای موجود، از جمله هزینههای بالا، کمبود نیروی انسانی متخصص و نیاز به رعایت استانداردهای پیچیده، این آزمایشگاهها باید به بهبود فرآیندها و بهرهبرداری از فناوریهای نوین بپردازند. برای مطالعه، خرید و دریافت اطلاعات بیشتر در مورد دانستنیهای پزشکی به سایت نوین طب مراجعه نمایید.
سؤالات متداول در مورد آزمایشگاه پاتوبیولوژی
- نتایج آزمایشهای پاتوبیولوژی چه زمانی آماده میشوند؟
زمان آمادهسازی نتایج بستگی به نوع آزمایش دارد، اما معمولاً بین چند روز تا یک هفته به طول میانجامد.
- آیا آزمایشهای پاتوبیولوژی بیخطر هستند؟
بله، جمعآوری نمونهها معمولاً بیخطر است، ولی ممکن است در برخی موارد عوارض جزئی وجود داشته باشد.
چگونه میتوان مطمئن شد که آزمایشهای پاتوبیولوژی بهدرستی انجام شدهاند؟
آزمایشگاههای معتبر تحت نظارت سازمانهای مربوطه قرار دارند و استانداردهای کیفی را رعایت میکنند. همچنین، نتایج باید توسط پزشک متخصص، تفسیر شوند.